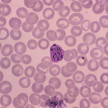
Malaria: Impfstoff erhöht Infektionsrisiko

Thema: Impfstoffe
Artikel zum Thema
Meningokokken-Impfstoffe Nimenrix: Pfizer kontingentiert nicht mehr
Die Vakzine gegen Meningokokken sind knapp. GlaxoSmithKline (GSK) kann den tetravalenten Impfstoff Menveo voraussichtlich erst wieder zum Jahresende liefern.... Mehr»
Baden-Württemberg Grippeimpfstoffe: Mylan-Monopol
Mylan ist der Gewinner der aktuellen Impfstoffausschreibung der AOK Baden-Württemberg. Ab Juli 2017 wird im Ländle zwei Jahre lang exklusiv der Grippeimpfstoff... Mehr»
Plasmodien-Erkrankung Malaria: Impfstoff erhöht Infektionsrisiko
Rückschlag im Kampf gegen Malaria: Der Impfstoff Mosquirix (RTS,S) von GlaxoSmithKline (GSK) erhöht womöglich nach einem initialen Schutz sogar das... Mehr»
Krebsvorsorge HPV-Impfung für Jungen?
Schon seit zehn Jahren ist der Impfstoff gegen Humane Papillomviren (HPV) in Europa zugelassen. HPV können bei Mädchen und Frauen unter anderem... Mehr»
Standardimpfungen Not-Importe gegen Impfstoff-Engpass
Der seit Monaten andauernde Lieferengpass bei den Fünffachimpfstoffen hat nun auch die Lager der 6er-Kombination geleert. Wie das Paul-Ehrlich-Institut (PEI)... Mehr»
Grippeimpstoffe Hersteller lassen AOK sitzen
Die AOK Baden-Württemberg hat bei ihrer Ausschreibung für Grippeimpfstoffe eine Schlappe kassiert: Für Vakzine ohne Kanüle ging laut Kasse kein zuschlagsfähiges... Mehr»
Pharmakonzerne MSD: Massenproduktion von Ebola-Impfstoff
Die weltweit erste Massenproduktion von Impfstoffen gegen das Ebola-Virus entsteht in Burgwedel bei Hannover. Der US-Pharmakonzern Merck & Co investiert rund 60... Mehr»
Impfungen Hepatitis A am Mittelmeer verbreitet
Wer Urlaub in der Mittelmeerregion macht, lässt sich vor der Abreise am besten gegen Hepatitis A impfen. Dieses Virus ist im Mittelmeerraum – wie in den Tropen... Mehr»
Kommentar Kinderimpfung greift zu kurz
Um die Impfmoral in Deutschland ist es nicht sonderlich gut bestellt. Auch in Apotheken taucht die Diskussion auf, ob Eltern die empfohlenen Immunisierungen für... Mehr»
In Berlin sind erneut die Masern ausgebrochen. Ein Fall pro Tag wird gemeldet, seit April sind es bereits mehr als 50. Ähnlich wie bei der Masern-Epidemie im... Mehr»
Medien zum Thema
- 1
- 2